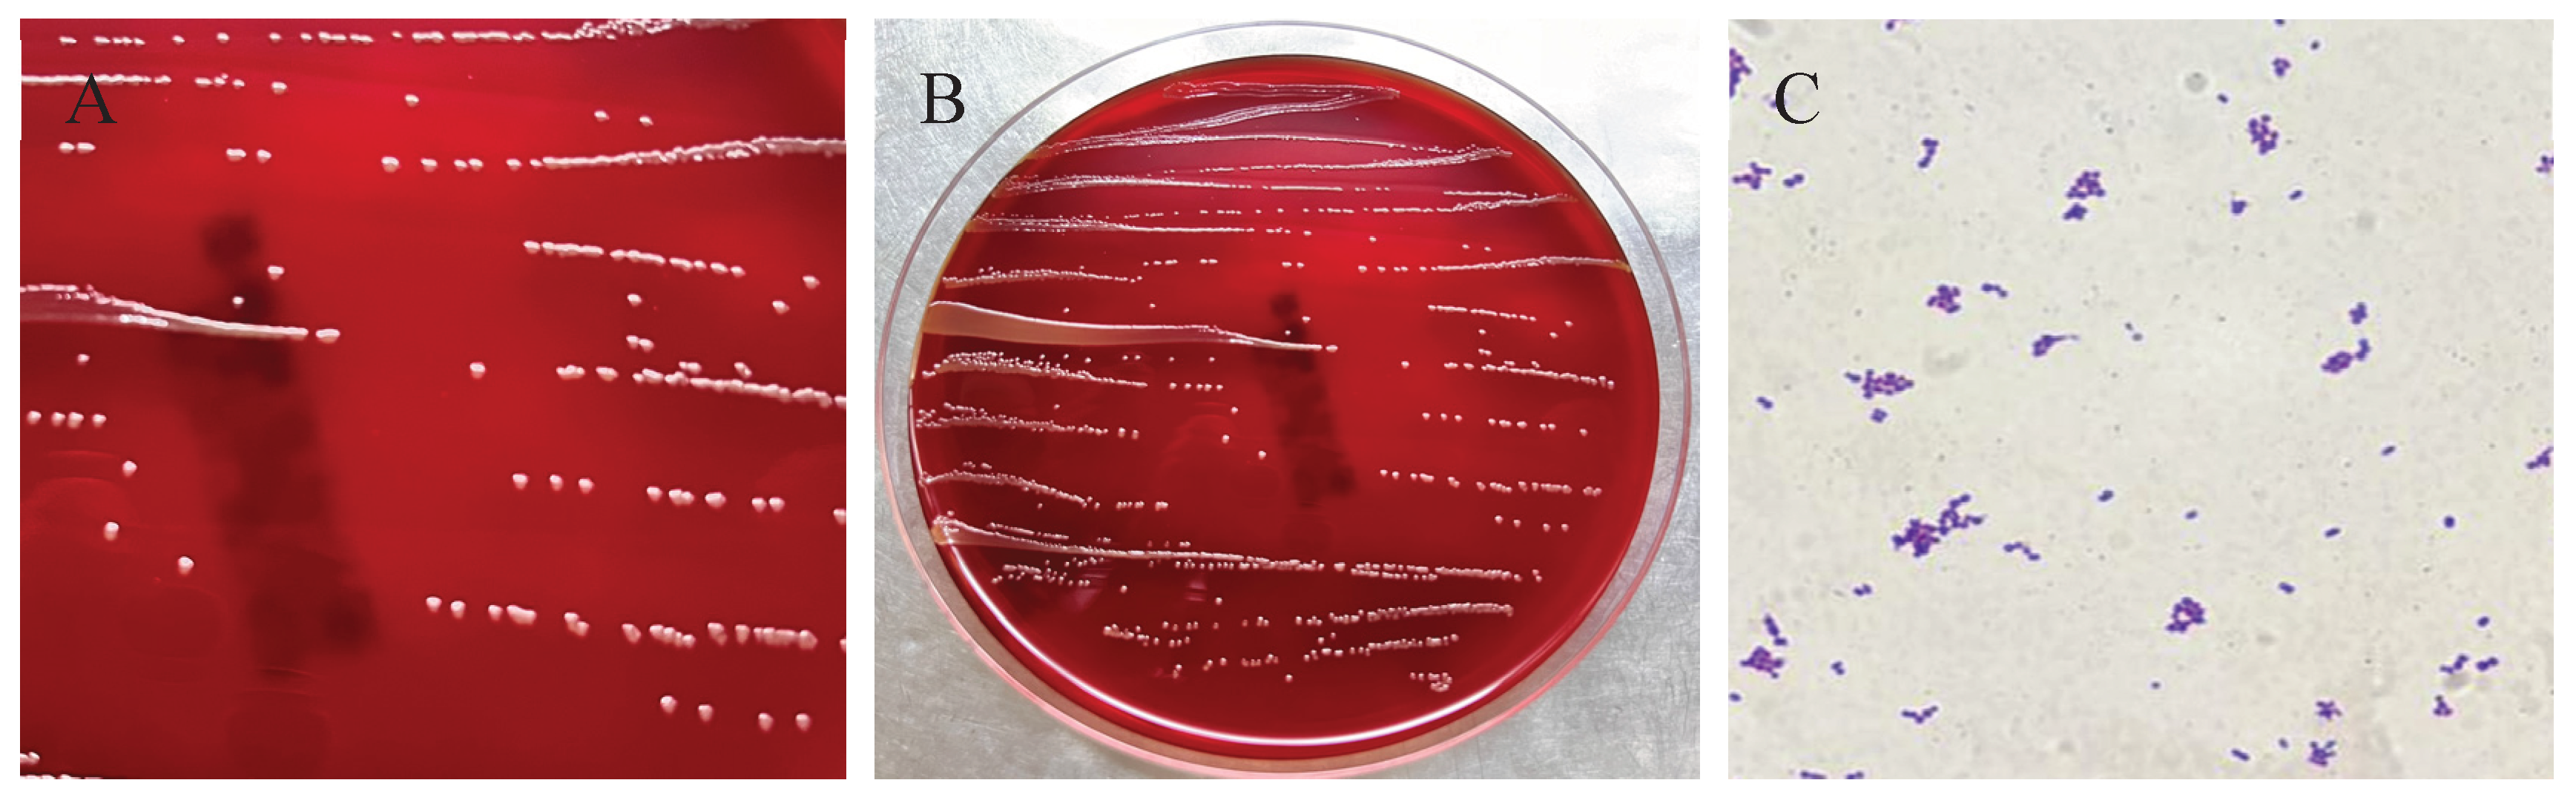
Preprints 177938 g003

Submitted:
23 September 2025
Posted:
24 September 2025
You are already at the latest version
Abstract
In May 2025, a female giraffe in poor body condition died unexpectedly at a zoo in Henan Province, China. A bacterial strain, designated HN-1, was isolated from the heart, liver, spleen, lungs, and kidneys of the deceased animal. After 24 hours of incubation at 37°C on Luria–Bertani (LB) agar, the colonies appeared round, smooth, pale yellow, translucent, and raised. Gram staining revealed that the isolate was a Gram-positive, rod-shaped, and non-spore-forming bacterium. Based on 16S rRNA gene sequencing, the strain showed more than 99.7% homology with reference sequences of E. mexicanum from various sources in GenBank. The results of the susceptibility test showed that E. mexicanum was susceptible to levofloxacin, clindamycin, chloramphenicol, trimethoprim, rifampicin, tetracycline, minocycline, gentamicin, erythromycin, and doxycycline, but resistant to oxacillin, penicillin, ciprofloxacin, and linezolid. These findings provide valuable insights for the diagnosis and treatment of infections caused by E. mexicanum in giraffes.
Keywords:
1. Introduction
2. Materials and Methods
2.1. Case Reports and Pathological Examination
2.2. Bacterial Isolation and Morphological Observation
2.3. Molecular Identification
2.4. Antibiotic Susceptibility Testing
3. Results
3.1. Clinical and Pathological Findings in the Deceased Giraffe
3.2. Histopathological Findings in the Deceased Giraffe
3.3. Bacterium Isolation and Microscopic Examination
3.4. Strain HN-1 Was Identified as E. mexicanum
3.5. Antimicrobial Susceptibility Detection
4. Discussion
5. Conclusions
Author Contributions
References
- Bashaw, M.J.; Tarou, L.R.; Maki, T.S.; Maple, T.L. A survey assessment of variables related to stereotypy in captive giraffe and okapi. Appl. Anim. Behav. Sci. 2001, 73, 235–247. [Google Scholar] [CrossRef] [PubMed]
- Kearney, C.C.; Ball, R.L.; Hall, M.B. Effects of altering diet carbohydrate profile and physical form on zoo-housed giraffe Giraffa camelopardalis reticulata. J. Anim. Physiol. Anim. Nutr. 2024, 108, 1119–1133. [Google Scholar] [CrossRef] [PubMed]
- Saito, M.; Matsunaga, M.; Fukuizumi, H.; Nakamichi, M.; Kinoshita, K. Factors affecting captive female giraffe stress response: Male presence, small enclosure, and low temperature. Zoo Biol. 2023, 42, 632–643. [Google Scholar] [CrossRef]
- Passos, L.F.; Garcia, G.; Young, R.J. Comparing the bacterial communities of wild and captive golden mantella frogs: Implications for amphibian conservation. PLOS ONE 2018, 13, e0205652. [Google Scholar] [CrossRef] [PubMed]
- Diaz, J.; Reese, A.T. Possibilities and limits for using the gut microbiome to improve captive animal health. Anim. Microbiome 2021, 3, 1–14. [Google Scholar] [CrossRef]
- Schmidt, D.A.; Barbiers, R.B.; Ellersieck, M.R.; Ball, R.L.; Koutsos, E.A.; Griffin, M.E.; Grobler, D.; Citino, S.B.; Bush, M. Serum Chemistry Comparisons Between Captive and Free-ranging Giraffes (Giraffa camelopardalis). J. Zoo Wildl. Med. 2011, 42, 33–39. [Google Scholar] [CrossRef]
- Hernández-Reyes, A.L.; Chávez-Gris, G.; Maldonado-Castro, E.; Alcaraz-Sosa, L.E.; Díaz-Negrete, M.T. First identification of Mycobacterium avium subsp. paratuberculosis in wild ruminants in a zoo in Mexico. Veter- World 2022, 15, 655–661. [Google Scholar] [CrossRef]
- Wang, J.; Wang, Y.; Ding, Y.; Suljid, J.; Wang, W. Oral and pulmonary necrobacillosis in a juvenile reticulated giraffe. J. Veter- Diagn. Investig. 2021, 33, 345–347. [Google Scholar] [CrossRef]
- Hlokwe, T.M.; Michel, A.L.; Mitchel, E.; Gcebe, N.; Reininghaus, B. First detection ofMycobacterium bovisinfection in Giraffe (Giraffa camelopardalis) in the Greater Kruger National Park Complex: Role and implications. Transbound. Emerg. Dis. 2019, 66, 2264–2270. [Google Scholar] [CrossRef]
- Armstrong, D.; Seddon, P. Directions in reintroduction biology. Trends Ecol. Evol. 2008, 23, 20–25. [Google Scholar] [CrossRef]
- Chen, X.; Wang, L.; Zhou, J.; Wu, H.; Li, D.; Cui, Y.; Lu, B. Exiguobacterium sp. A1b/GX59 isolated from a patient with community-acquired pneumonia and bacteremia: genomic characterization and literature review. BMC Infect. Dis. 2017, 17, 1–7. [Google Scholar] [CrossRef]
- Shen, L.; Liu, Y.; Chen, L.; Lei, T.; Ren, P.; Ji, M.; Song, W.; Lin, H.; Su, W.; Wang, S.; et al. Genomic basis of environmental adaptation in the widespread poly-extremophilic Exiguobacterium group. ISME J. 2024, 18. [Google Scholar] [CrossRef]
- López-Cortés, A.; Schumann, P.; Pukall, R.; Stackebrandt, E. Exiguobacterium mexicanum sp. nov. and Exiguobacterium artemiae sp. nov., isolated from the brine shrimp Artemia franciscana. Syst. Appl. Microbiol. 2006, 29, 183–190. [Google Scholar] [CrossRef] [PubMed]
- Lei, J.; Zheng, M.; Wang, L.; Yin, G.; Lou, Y.; Shi, L. Complete genome sequence of Exiguobacterium mexicanum A-EM, isolated from seafloor hydrothermal vents in Atlantic Ocean. Mar. Genom. 2021, 55, 100801. [Google Scholar] [CrossRef] [PubMed]
- Exiguobacterium, Sp. HA2, isolated from the Ilam Mountains of IranReza Heidari, Mostafa Akbariqomi, Gholamreza Tavoosidana, Garshasb RigibioRxiv 2021. 03.12.43 5112. [CrossRef]
- Remonsellez, F.; Castro-Severyn, J.; Pardo-Esté, C.; Aguilar, P.; Fortt, J.; Salinas, C.; Barahona, S.; León, J.; Fuentes, B.; Areche, C.; et al. Characterization and Salt Response in Recurrent Halotolerant Exiguobacterium sp. SH31 Isolated From Sediments of Salar de Huasco, Chilean Altiplano. Front. Microbiol. 2018, 9, 2228. [Google Scholar] [CrossRef]
- Erofeevskaia, L. A. , Popova, L. L., & Saltycova, A. L. (2016). PROPERTIES OF STRAIN OF EXIGUOBACTERIUM MEXICANUM. [CrossRef]
- Abdulkarem, A.T.; Hasan, A.A.; Khudhur, H.R.; Abed, S.M. Overview of Opportunistic Bacteria. Karbala J. Pharm. Sci. 2024, 14, 11–21. [Google Scholar] [CrossRef]
- Li, H.; Qian, Z.; Yan, Y.; Wang, H. Isolation, Identification, and Drug Sensitivity Test of Pseudomonas aeruginosa from Cynomolgus Monkey (Macaca fascicularis). Veter- Sci. 2025, 12, 636. [Google Scholar] [CrossRef]
- Khalafalla, A.I. Zoonotic diseases transmitted from the camels. Front. Veter- Sci. 2023, 10, 1244833. [Google Scholar] [CrossRef]
- Zhao, C.; Qin, P.; Li, S.; Chen, Z.; Wang, T.; Liang, Q.; He, W.; Peng, Z.; Yang, Y.; Peng, Z.; et al. Exploring Aeromonas dhakensis in Aldabra giant tortoises: a debut report and genetic characterization. BMC Microbiol. 2024, 24, 1–10. [Google Scholar] [CrossRef]
- Shen, L.; Liu, Y.; Chen, L.; Lei, T.; Ren, P.; Ji, M.; Song, W.; Lin, H.; Su, W.; Wang, S.; et al. Genomic basis of environmental adaptation in the widespread poly-extremophilic Exiguobacterium group. ISME J. 2024, 18. [Google Scholar] [CrossRef]
- Zhang, D.; Zhu, Z.; Li, Y.; Li, X.; Guan, Z.; Zheng, J. Comparative Genomics of Exiguobacterium Reveals What Makes a Cosmopolitan Bacterium. mSystems 2021, 6, e0038321. [Google Scholar] [CrossRef] [PubMed]
- Pitt, T.; Malnick, H.; Shah, J.; Chattaway, M.; Keys, C.; Cooke, F.; Shah, H. Characterisation of Exiguobacterium aurantiacum isolates from blood cultures of six patients. Clin. Microbiol. Infect. 2007, 13, 946–948. [Google Scholar] [CrossRef]
- Ed-Dra, A.; Abdallah, E.M.; Sulieman, A.M.E.; Anarghou, H. Harnessing medicinal plant compounds for the control of Campylobacter in foods: a comprehensive review. Veter- Res. Commun. 2024, 48, 2877–2900. [Google Scholar] [CrossRef]
- Stephenson, M.M.; Coleman, M.E.; Azzolina, N.A. Trends in Burdens of Disease by Transmission Source (USA, 2005–2020) and Hazard Identification for Foods: Focus on Milkborne Disease. J. Epidemiology Glob. Heal. 2024, 14, 787–816. [Google Scholar] [CrossRef]
- Kamel, M.S.; Davidson, J.L.; Verma, M.S. Strategies for Bovine Respiratory Disease (BRD) Diagnosis and Prognosis: A Comprehensive Overview. Animals 2024, 14, 627. [Google Scholar] [CrossRef]
- Kamel, M.S.; Davidson, J.L.; Verma, M.S. Strategies for Bovine Respiratory Disease (BRD) Diagnosis and Prognosis: A Comprehensive Overview. Animals 2024, 14, 627. [Google Scholar] [CrossRef]
- Nakov, D.; Hristov, S.; Stankovic, B.; Pol, F.; Dimitrov, I.; Ilieski, V.; Mormede, P.; Hervé, J.; Terenina, E.; Lieubeau, B.; et al. Methodologies for Assessing Disease Tolerance in Pigs. Front. Veter- Sci. 2019, 5, 329. [Google Scholar] [CrossRef] [PubMed]
- Kasana, R.C.; Pandey, C.B. Exiguobacterium: an overview of a versatile genus with potential in industry and agriculture. Crit. Rev. Biotechnol. 2017, 38, 141–156. [Google Scholar] [CrossRef]
- Cui, Y.; Cui, Y.-W.; Huang, J.-L. A novel halophilic Exiguobacterium mexicanum strain removes nitrogen from saline wastewater via heterotrophic nitrification and aerobic denitrification. Bioresour. Technol. 2021, 333, 125189. [Google Scholar] [CrossRef] [PubMed]
- Iyer, R.; Damania, A. Draft Genome Sequence of Exiguobacterium sp. KKBO11, Isolated Downstream of a Wastewater Treatment Plant in Houston, Texas. Genome Announc. 2016, 4, e00681–16. [Google Scholar] [CrossRef]
- Sabnis, A.; Hagart, K.L.; Klöckner, A.; Becce, M.; E Evans, L.; Furniss, R.C.D.; Mavridou, D.A.; Murphy, R.; Stevens, M.M.; Davies, J.C.; et al. Colistin kills bacteria by targeting lipopolysaccharide in the cytoplasmic membrane. eLife 2021, 10, e65836. [Google Scholar] [CrossRef]
- Yuan, X.; Lv, Z.; Zhang, Z.; Han, Y.; Liu, Z.; Zhang, H. A Review of Antibiotics, Antibiotic Resistant Bacteria, and Resistance Genes in Aquaculture: Occurrence, Contamination, and Transmission. Toxics 2023, 11, 420. [Google Scholar] [CrossRef]
- Fastl, C.; Ferreira, H.C.D.C.; Martins, S.B.; Afonso, J.S.; di Bari, C.; Venkateswaran, N.; Pires, S.M.; Mughini-Gras, L.; Huntington, B.; Rushton, J.; et al. Animal sources of antimicrobial-resistant bacterial infections in humans: a systematic review. Epidemiology Infect. 2023, 151, 1–31. [Google Scholar] [CrossRef]
- Bai, Y.; Wang, Q.; Liu, M.; Bian, L.; Liu, J.; Gao, F.; Mao, Q.; Wang, Z.; Wu, X.; Xu, M.; et al. The next major emergent infectious disease: reflections on vaccine emergency development strategies. Expert Rev. Vaccines 2022, 21, 471–481. [Google Scholar] [CrossRef] [PubMed]
- Levings, R.L. Emerging and Exotic Zoonotic Disease Preparedness and Response in the United States – Coordination of the Animal Health Component. Zoonoses Public Heal. 2012, 59, 80–94. [Google Scholar] [CrossRef] [PubMed]
- Cohn, J.; Mendelson, M.; Kanj, S.S.; Shafiq, N.; Boszczowski, I.; Laxminarayan, R. Accelerating antibiotic access and stewardship: a new model to safeguard public health. Lancet Infect. Dis. 2024, 24, e584–e590. [Google Scholar] [CrossRef] [PubMed]

| Antibiotics | Medication Dose (ug/disc) |
IZD (mm) | Sensitivity | Judgment Standard of Inhibition Zone Diameter (mm) | ||
|---|---|---|---|---|---|---|
| Resistant | Intermediate | Sensitive | ||||
| Gentamicin | 10 | 21.1 | S | ≤12 | 13~14 | ≥15 |
| Ciprofloxacin | 5 | 12.4 | R | ≤15 | 16~20 | ≥21 |
| Chloramphenicol | 30 | 24 | S | ≤12 | 13~17 | ≥18 |
| Erythromycin | 15 | 20.5 | I | ≤13 | 14~22 | ≥23 |
| Doxycycline | 30 | 21 | S | ≤12 | 13~15 | ≥16 |
| Levofloxacin | 5 | 20 | S | ≤15 | 16~18 | ≥19 |
| Tetracycline | 30 | 26 | S | ≤14 | 15~18 | ≥19 |
| Minocycline | 30 | 27 | S | ≤14 | 15~18 | ≥19 |
| Trimethoprim | 5 | 10.5 | I | ≤10 | 11~15 | ≥16 |
| Clindamycin | 2 | 22 | S | ≤14 | 15~20 | ≥21 |
| Linezolid | 30 | 15.2 | R | ≤22 | 23~25 | ≥26 |
| Rifampicin | 5 | 17 | I | ≤16 | 17~19 | ≥20 |
| Oxacillin | 1 | 9.7 | R | ≤24 | — | ≥25 |
| Penicillin | 10 | 16.6 | R | ≤28 | — | ≥29 |
Disclaimer/Publisher’s Note: The statements, opinions and data contained in all publications are solely those of the individual author(s) and contributor(s) and not of MDPI and/or the editor(s). MDPI and/or the editor(s) disclaim responsibility for any injury to people or property resulting from any ideas, methods, instructions or products referred to in the content. |
© 2025 by the authors. Licensee MDPI, Basel, Switzerland. This article is an open access article distributed under the terms and conditions of the Creative Commons Attribution (CC BY) license (http://creativecommons.org/licenses/by/4.0/).
